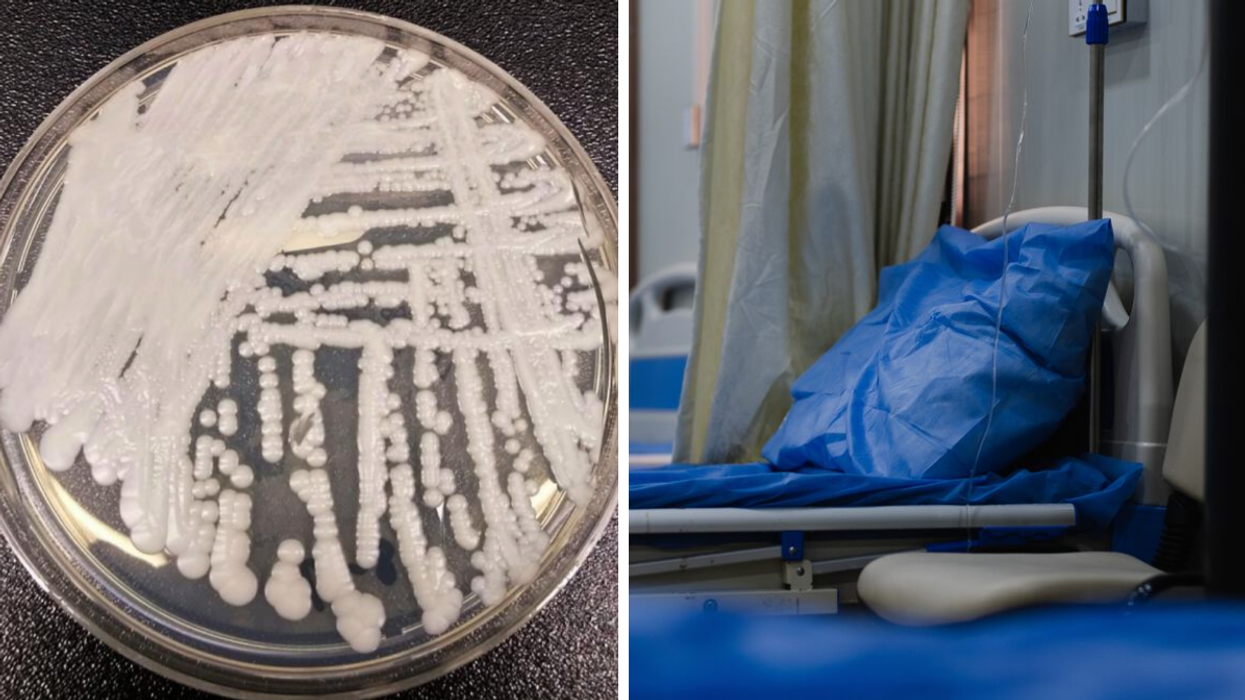

Un champignon mortel se répand aux États-Unis et ça préoccupe les experts au Québec
« Le Québec n'est pas à l'abri... »
Le champignon Candida auris. Droite : Lit d'hôpital.
Un champignon dangereux, le Candida auris, se propage à grande vitesse aux États-Unis depuis les derniers mois et cette évolution inquiète tant au Canada qu'au Québec. Alors que les dépistages se multiplient, le C. Auris circule rapidement dans les établissements de santé et peut causer des infections graves avec des taux de mortalité élevés.
Selon ce que le Center for Disease Control (CDC) a indiqué ce 20 mars 2023, il s'agit d'une menace dite urgente en raison de sa capacité de résistance aux traitements. En 2022, ce sont 2 377 cas cliniques et 5 754 cas de dépistage qui ont été recensés au pays de l'Oncle Sam.
Au moment où le nombre d'infections augmente chez nos voisin.es du Sud, Narcity s'est renseigné auprès de l'Institut national de santé publique du Québec (INSPQ pour en savoir plus sur la situation au Québec. Il semblerait que les autorités sanitaires de la province surveillent avec attention cette propagation.
« Il s’agit en effet d’une nouvelle menace infectieuse sérieuse pour nos milieux de soins, particulièrement pour nos patients vulnérables en soins de longue durée ou soins intensifs », affirme le spécialiste clinique en biologie médicale à l'INSPQ, Philippe Dufresne, à Narcity.
Terreur des hôpitaux, cette levure est très résistante aux médicaments antifongiques et peut être transmise dans les centres de soin de santé qui sont pourtant régulièrement aseptisés. « On estime que 5 à 10 % des patients colonisés [par C. auris] finiront par subir une infection grave et que la mortalité peut être assez élevée chez ces patients vulnérables (autour de 45 %) », explique Philippe Dufresne.
Bien que le Canada compte peu de cas depuis 2012, soit 43 donc cinq au Québec, la santé publique reste tout de même en alerte. L'INSPQ assure que des mesures ont été mises en place dans les laboratoires et les hôpitaux afin de dépister et identifier le champignon pour éviter sa propagation.
« On redoute son arrivée au Québec dans nos milieux de soins, par des voyages et patients hospitalisés à l’étranger. Le Québec n’est pas à l’abri, mais il s’y prépare depuis 2016 », affirme Philippe Dufresne.
Le spécialiste tient à rassurer la population en affirmant que la province est loin d'être à la veille d'une nouvelle crise sanitaire. « Le C. auris ne se transmet pas comme la COVID, mais il faut rester vigilant pour pour freiner C. auris dans nos milieux de soins et protéger nos patients à risque », conclut-il.
Quels sont les symptômes du Candida auris?
Selon le gouvernement du Québec, les symptômes associés à ce champignon peuvent varier selon l'endroit infecté. « Le Candida auris peut notamment causer une infection du sang, d’une plaie, de l’oreille, des voies urinaires, des os ou des méninges (enveloppe du cerveau) », peut-on lire.
Les personnes infectées peuvent subir de graves complications et même présenter un danger de mort. Le Candida auris se transmet par contact direct avec un patient ou une patiente contaminé.e ou de manière indirecte avec des objets ou des surfaces.